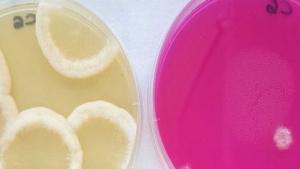

Biocastanea 2016 le invita a participar en el VII Gran Magosto Solidario en beneficio de Asprona Bierzo
La Mesa del Castaño del Bierzo organiza el VII Gran Magosto Solidario el próximo día 19 de noviembre de 2016 a las 19h en el marco de la VII Feria de la Castaña, Biocastanea 2016. Este Magosto es una de las múltiples actividades que llenarán El Bierzo entre el 16 y el 20 de noviembre, y que incluye las jornadas técnicas, las demostraciones técnicas y la propia Feria de la Castaña, además de actividades complementarias para todas las edades.
VII Gran Magosto Solidario
Este año, como novedad, el Gran Magosto Popular que se celebra cada año en Biocastanea tendrá un objetivo solidario y la pretensión de que en las siguientes ediciones se beneficie una entidad solidaria diferente de las aportaciones que se consigan con su celebración.
En esta edición, la primera solidaria, las aportaciones recibidas irán destinadas a ASPRONA BIERZO, una organización sin ánimo de lucro destinada a cubrir las necesidades de personas con discapacidad intelectual y sus familias, con el fin de mejorar sus calidades de vida. Para ello desarrollan varias líneas de trabajo encaminadas a la integración social y laboral de estas personas en riesgo de exclusión, la atención global de sus necesidades, la representación conjunta de esta entidad ante las instituciones públicas y privadas sobre intereses comunes, y por último, sensibilizar a la ciudadanía de las necesidades de las personas con discapacidad y sus familias.
Descubre Biocastanea 2016
La VII Feria de la Castaña, Biocastanea 2016, está organizado por la Mesa del Castaño del Bierzo y pretende promover la revitalización del sector de la castañicultura, concienciar de la importancia de la supervivencia de esta especie para Castilla y León y la comarca de El Bierzo como elemento cultural, paisajístico, ambiental y económico.
Como ya viene siendo habitual, Biocastanea estará formado por un triple escenario: las Jornadas Técnicas (17-19 de noviembre en el Campus de Ponferrada – Universidad de León y en el Auditorio del Recinto Ferial de Carracedelo), la Feria de la Castaña (18-20 de noviembre en el Recinto Ferial de Carracedelo), y las Demostraciones Técnicas (19 de noviembre en el Soto de Corullón). De manera paralela se celebrará un amplio abanico de actividades complementarias orientadas a públicos de todas las edades, entre las que se encuentran:
- VII Concentración de gaiteros
- Conferencia “Producción y gestión integrada del castaño”
- Presentación del proyecto de la Red Biocastanea de Sotos Sostenibles
- Talleres de cocina con castaña para niños “Cocina castaña en familia”
- III Biocaastanea Showcooking
- Taller para niños “Iniciación al arte con flor de castaño”
- Taller de Cestería de castaño para niños
- VII Gran Magosto Solidario en beneficio de Asprona Bierzo
- VII Biocastanea Music Festival
- II Cata Biocastanea: Cata de vino envejecido en barricas de madera de castaño y cata de cervezas
- Entrega de los VII Premios Biocastanea
- VII Biocastanea Folk Festival
La VII Feria de la Castaña, Biocastanea 2016, está organizada por la Mesa del Castaño del Bierzo. En esta edición está patrocinada por la Junta de Castilla y León, la Diputación de León, el Ayuntamiento de Carracedelo, la Marca de Garantía Castaña del Bierzo, Cesefor, el Consejo Comarcal del Bierzo y Productos de León.